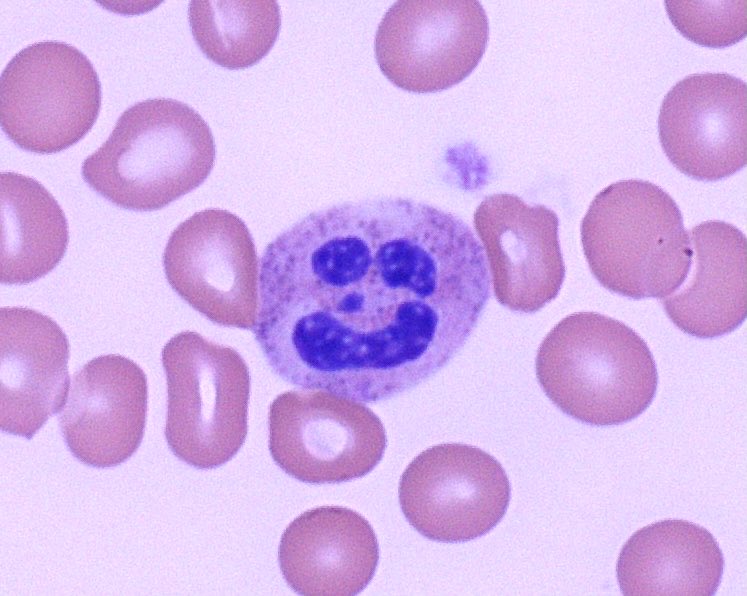
Chad McCall tweet media

Chad McCall
32 posts




@DrJosephKim @Sara_Jiang yes, we have used Beaker for 2.5 years. No, not helping much!
English

@evemariecrane #pathJC we aren't there yet. EMR (Epic) logistics are tricky. I put addenda in if molecular or cytog clarifies dx
English
Chad McCall retweetledi

@feldstej @evemariecrane at least at @DukePathDept the cytochemical stain is at least as reliable and fast as flow cytoplasmic MPO...
English

@evemariecrane #PathJC we use MPO cytochemical on every new acute leuk and it has been quite helpful. Not antiquated at all.
English

@david_terrano @Sara_Jiang @drmattdenicola @evemariecrane absolutely. Having my onc friends next door helps a correct and quick dx
English

@evemariecrane #PathJC it is for us. I wonder about leaving them unstained and save unless the aspirate smear is poor, but we look at 2.
English

@CArnold_GI @Sara_Jiang @evemariecrane my little helper also has clear opinions about #hemepath (stop Tweeting and play)

English

@Sara_Jiang @path_JC #pathJC I ask because I see a lot of unnecessary testing and missed testing but dread the extra work!
English

@Sara_Jiang @jrstumph @DukePathDept but it was still separate at Hopkins when @evemariecrane and I were there
English

@evemariecrane @LilDocLiz1 @FRodriguezNP @Sara_Jiang I'm wondering how many pathologists directly order ancillary tests for acute leukemia.
English

Why we have to be very careful--and often hedge--in diagnosing myelodysplastic syndrome. twitter.com/bloodjournal/s…
Blood Journals Portfolio@BloodPortfolio
Blood Work: Stress dyspoiesis secondary to sepsis and extracorporeal membrane oxygenation ow.ly/X1Wb3047YvE
English